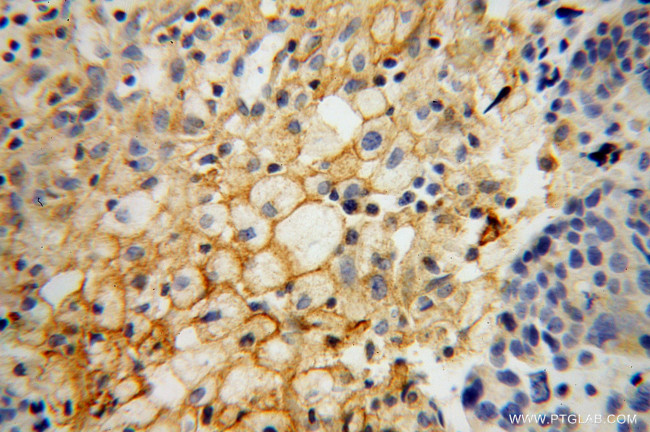
HSD17B2 Antibody in Immunohistochemistry (Paraffin) (IHC (P))

Search
Proteintech
HSD17B2 Polyclonal Antibody
{{$productOrderCtrl.translations['antibody.pdp.commerceCard.promotion.promotions']}}
{{$productOrderCtrl.translations['antibody.pdp.commerceCard.promotion.viewpromo']}}
{{$productOrderCtrl.translations['antibody.pdp.commerceCard.promotion.promocode']}}: {{promo.promoCode}} {{promo.promoTitle}} {{promo.promoDescription}}. {{$productOrderCtrl.translations['antibody.pdp.commerceCard.promotion.learnmore']}}
产品信息
10978-1-AP
种属反应
已发表种属
宿主/亚型
分类
类型
抗原
偶联物
形式
浓度
规格
纯化类型
保存液
内含物
保存条件
运输条件
产品详细信息
Immunogen sequence: MSTFFSDTA WICLAVPTVL CGTVFCKYKK SSGQLWSWMV CLAGLCAVCL LILSPFWGLI LFSVSCFLMY TYLSGQELLP VDQKAVLVTG GDCGLGHALC KYLDELGFTV FAGVLNENGP GAEELRRTCS PRLSVLQMDI TKPVQIKDAY SKVAAMLQDR GLWAVINNAG VLGFPTDGEL LLMTDYKQCM AVNFFGTVEV TKTFLPLLRK SKGRLVNVSS MGGGAPMERL ASYGSSKAAV TMFSSVMRLE LSKWGIKVAS IQPGGFLTNI AGTSDKWEKL EKDILDHLPA EVQEDYGQDY ILAQRNFLLL INSLASKDFS PVLRDIQHAI LAKSPFAYYT PGKGAYLWIC LAHYLPIGIY DYFAKRHFGQ DKPMPRALRM PNYKKKAT (1-387 aa encoded by BC009581)
靶标信息
HSD17B2 is capable of catalyzing the interconversion of testosterone and androstenedione, as well as estradiol and estrone. HSD17B2 also has 20-alpha-HSD activity. HSD17B2 uses NADH while EDH17B3 uses NADPH.
仅用于科研。不用于诊断过程。未经明确授权不得转售。
生物信息学
蛋白别名: 1.1.1.239; 17 beta HSD 2; 17-beta-HSD 2; 17-beta-hydroxysteroid dehydrogenase type 2; 20 alpha HSD; 20 alpha-hydroxysteroid dehydrogenase; 20-alpha-HSD; E2DH; Estradiol 17-beta-dehydrogenase 2; Microsomal 17-beta-hydroxysteroid dehydrogenase; Short chain dehydrogenase/reductase family 9C member 2; tes; Testosterone 17-beta-dehydrogenase; unnamed protein product
基因别名: EDH17B2; HSD17; HSD17B2; SDR9C2
UniProt ID: (Human) P37059
Entrez Gene ID: (Human) 3294